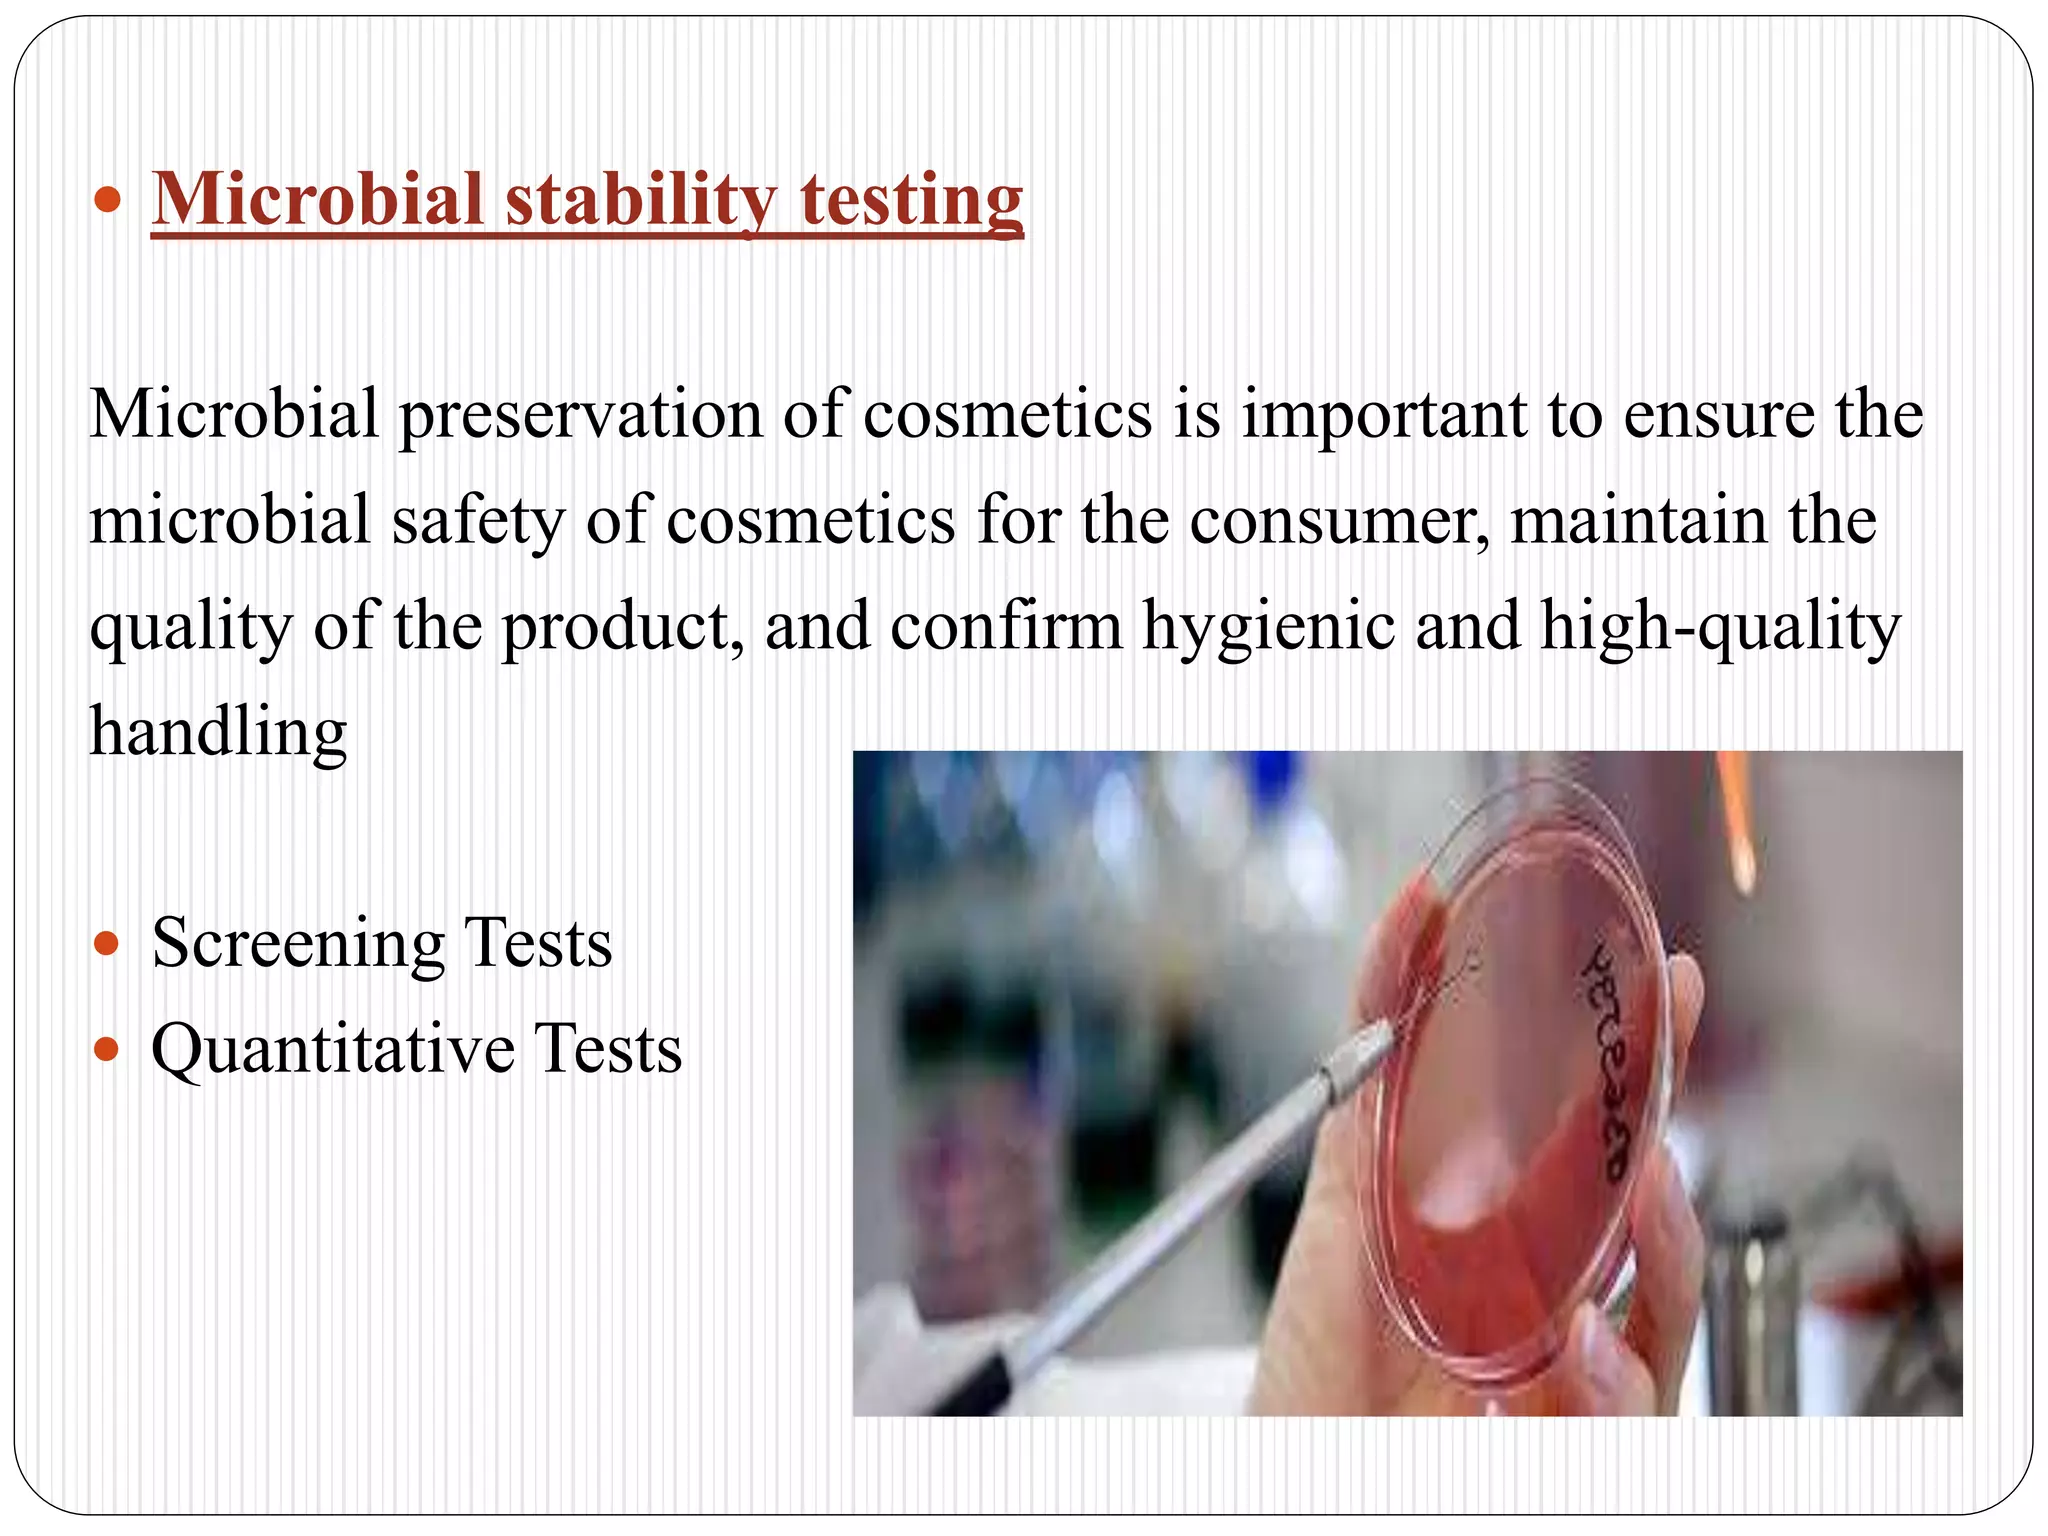
 Microbial stability testing
Microbial preservation of cosmetics is important to ensure the
microbial safety of cosmetics for the consumer, maintain the
quality of the product, and confirm hygienic and high-quality
handling
 Screening Tests
 Quantitative Tests

The document discusses analysis, toxicity screening, and testing methods for cosmetics. It covers the following key points:
1. Physical, chemical, and microbiological evaluations are used to analyze cosmetics, including tests of rheology, stability, preservatives, packaging, residues, heavy metals, and arsenic.
2. Toxicity studies include acute toxicity tests, percutaneous absorption studies, skin and eye irritation tests, sensitization studies, subchronic toxicity analysis, and mutagenicity/genotoxicity assessments.
3. Additional tests evaluate phototoxicity, photomutagenicity, and photogenotoxicity due to UV-absorbing ingredients in cosmetics. Reference